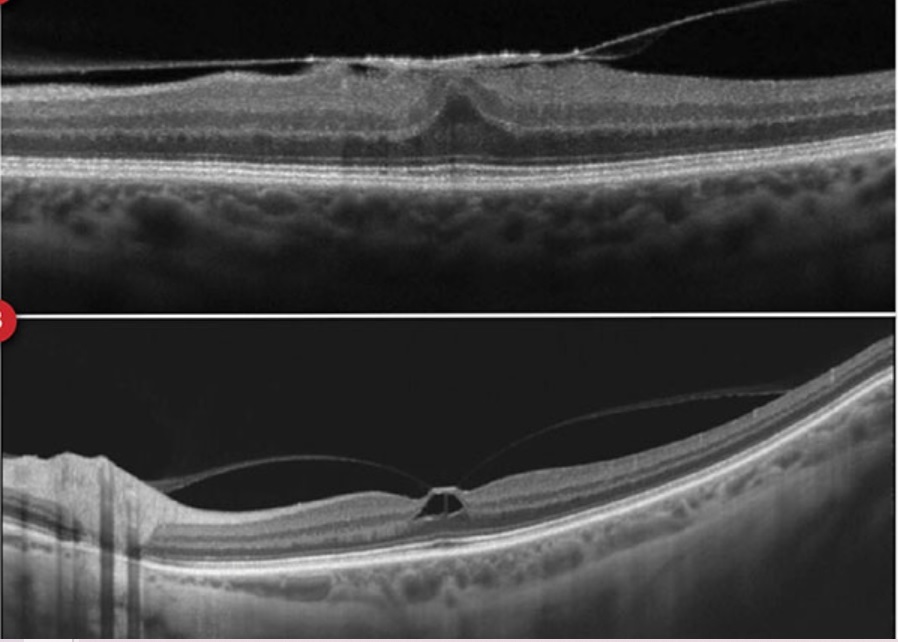

Qual é a fisiopatologia da Membrana Epirretiniana (MER)?
- Hialócitos remanescentes sobre a mácula, após o DPV, proliferam, associados à células gliais, formando uma membrana que distorce a arquitetura da retina.

Qual é a forma mais prevalente de MER?
Idiopática
- 2% acima de 50 anos
- 20% acima dos 75 anos
Qual é a prevalência de bilateralidade da MER idiopática?
10-20% dos casos
Quais são as principais etiologias das MERs secundárias?
- Descolamento de Retin
- HV
- Uveítes
- Fotocoagulação a laser
- Crioterapia
Qual é o quadro clínico apresentado pelos pacientes com MER?
Metamorfopsia (principal sintoma)
MER em celofane (quadro leve)
- 66% com AV > 20/30
- 5% com AV<20/30
Pucker Macular (quadro avançado)
- pós-cirúrgico –> distorção vascular
- BAV importante

Qual é a classificação da MER?
Estágio I: Depressão foveal preservada
Estágio II: Perda da depressão foveal
Estágio III: Ectopia das camadas internas
Estágio IV: Perda da distinção das camadas da retina

O que é o Pseudo-buraco de Mácula?
Distorção da região foveal, causada por uma MER, que gera impressão de um Buraco de Mácula, porém, sem acometer a espessura total da retina.

Qual é o tratamento indicado para a MER?
- AV> 20/40: Observação
- AV<20/40 // Metamorfopsia: VVPP com Peeling da MER
Quais são as substâncias utilizadas para identificação da MER durante a cirurgia de VVPP?
Triancinolona
Azul de Trypan

O que é a Síndrome de Tração Vítreomacular?
- DVP parcial, com forte adesão na região macular, associada a tração nesta região, distorcendo a arquitetura local.

Qual é o quadro clínico apresentando pelos pacientes com STVM?
Edema Cistóide
Descolamento da fóvea
Buracos lamelares

O que é um Buraco Lamelar?
Defeirto retiniano de espessura parcial, gerado pela forte tração e adesão do vítreo na região foveal.
NÃO é indicação de tratamento cirurgico.

Qual é a classificação da STVM?
Adesão Vítreomacular: sem distorção da arquitetura macular
STVM Focal: adesão menor 1500 micrômetros
STVM Difusa: adesão maior 1500 micrômetros
Qual é o tratamento da STVM?
- Casos leves: observação:
- Casos sintomáticos graves: VVPP com Peeling de MLI
Qual corante utilizamos para corar a Membrana Limitante Interna (MLI)?
Azul Brilhante
Indocianina Verde ou Infracianina Verda

Qual é a taxa de resolução espontânea dos casos de STVM?
50% se resolvem espontaneamente após o descolamento da hialóide posterior
O que é a Ocreoplasmina?
Enzima utilizada para promover o DVP em pacientes com STVM
Resolução em 1/3 dos casos
Qual é a epidemiologia dos Buracos Maculares?
Mulheres > Homens (2:1)
6ª-8ª décadas de vida
Bilateral em 10% dos casos
Qual é o quadro clínico dos pacientes com Buraco de Mácula?
Escotoma central absoluto
BAV

O que é o Sinal de Watzke-Allen?
Visualização de uma Faixa de Luz com uma interrupção no meio, pelo paciente com BM, quando iluminamos a região macular com uma iluminação em fenda.

Qual é a classificação do Buraco de Macula?
Classificação de Gass

Estágio 1: Buraco macular iminente
- 1a: Pseudocisto foveal
- 1b: Descontinuidade da retina externa (até 300 micrômetros)
Estágio 2: BM<400 micrômetros + Hialóide aderida à fóvea
Estágio 3: BM > 400 micrômetros + Hialóide solta da fóvea mas permanece aderida ao disco
Estágio 4: BM + DVP completo
Qual é o tratamento para o BM?
- Estágios 1a e 1b: observação
- Estágio 2, 3 e 4: VVPP + Peeling de MLI + Gás + orientação para o paciente ficar olhando para baixo (face down)


